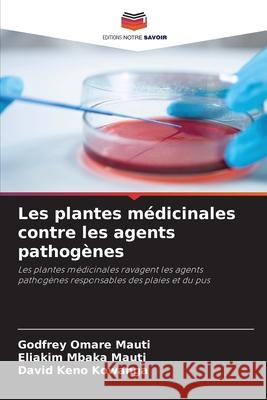
Les plantes médicinales contre les agents pathogènes Omare Mauti, Godfrey, Mauti, Eliakim Mbaka, Kowanga, David Keno 9786206150343 Editions Notre Savoir - książka

Les plantes médicinales contre les agents pathogènes » książka
topmenu
Les plantes médicinales contre les agents pathogènes
ISBN-13: 9786206150343 / Francuski / Miękka / 2026 / 52 str.
La septicémie des plaies est un aspect très important des soins chirurgicaux. La connaissance des agents pathogènes bactériens associés aux plaies infectées est essentielle pour déterminer leur suppression et leur contrôle. Dans cet ouvrage, nous découvrons comment les plantes médicinales (ail Allium sativum, tulsi ; Ocimum sanctum bitter guard ; Momordica charantia et cannelle ; Cinnamomum verum), que l'on trouve localement sur les marchés et sous forme d'herbes, ont une activité antibactérienne et antagoniste contre les bactéries présentes dans les plaies et le pus.